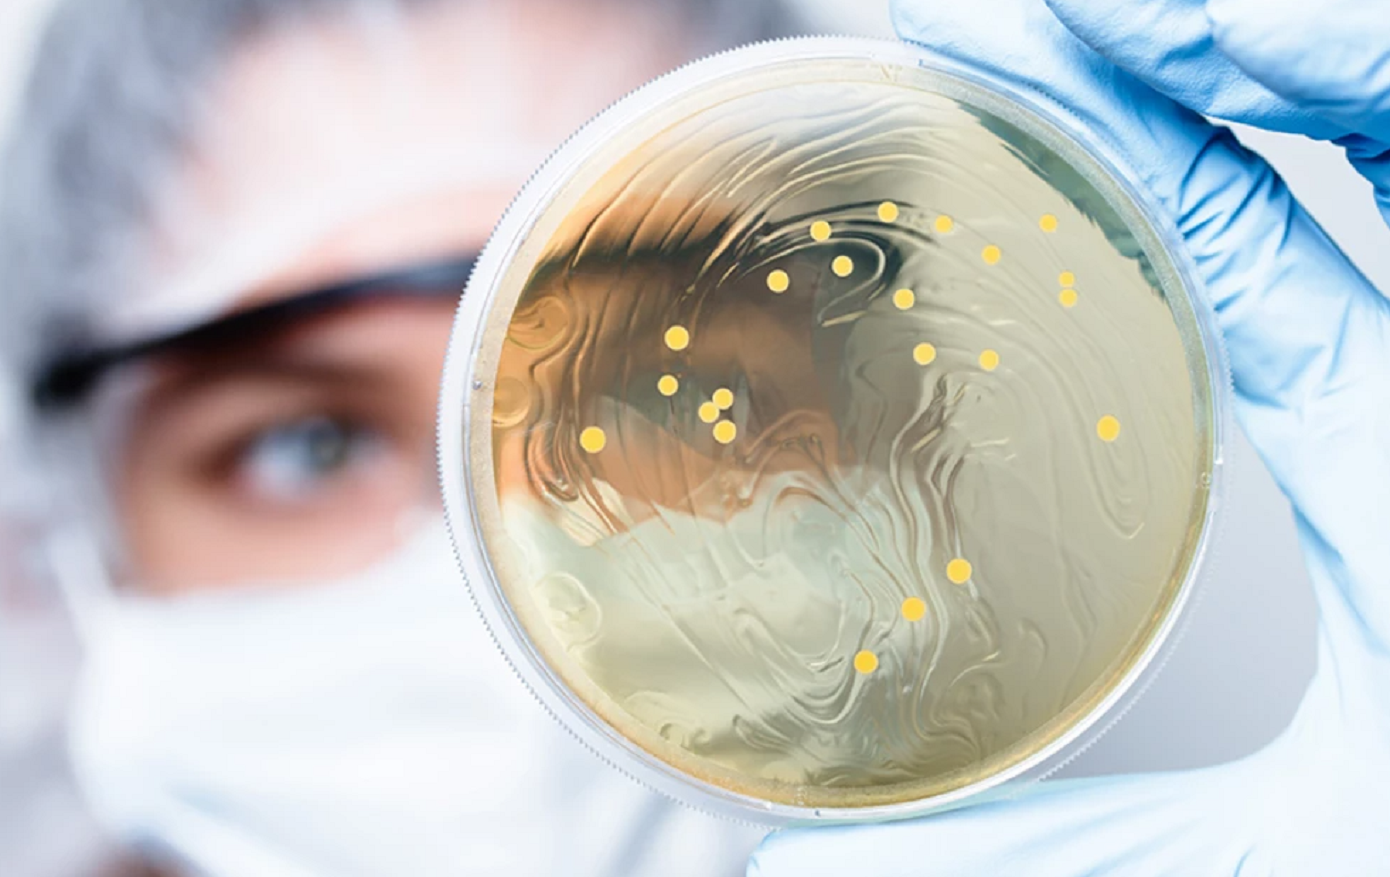

Επείγουσα προειδοποίηση εξέδωσαν 38 επιστήμονες που έχουν βραβευτεί με Νόμπελ για τα «βακτήρια καθρέφτες» που αναπτύχθηκαν σε εργαστήρια και θα μπορούσαν να εξαφανίσουν την ανθρωπότητα.
Σύμφωνα με δημοσίευμα της Daily Mail, είναι συνθετικοί οργανισμοί οι οποίοι κατασκευάζονται από αντικατοπτρισμένες εκδοχές των μορίων που βρίσκονται στη φύση. Εάν ξεφύγουν από το εργαστήριο, δεν θα υπήρχε τίποτα που να τους εμποδίζει να εγκατασταθούν στην άγρια φύση και να απειλήσουν φυτά, ζώα και ανθρώπους με θανατηφόρες λοιμώξεις.
Μια ομάδα 38 βραβευθέντων με Νόμπελ και άλλων ειδικών που έχουν προσπαθήσει να δημιουργήσουν «ζωή – καθρέφτη», ζητούν τώρα να σταματήσουν όλες οι νέες έρευνες.
Οι επιστήμονες ζήτησαν να σταματήσει η δημιουργία «βακτηρίων καθρέφτη», καθώς αυτά θα μπορούσαν να παρακάμψουν τις ανοσολογικές άμυνες όλης της ζωής στη Γη και να οδηγήσουν σε θανατηφόρες λοιμώξεις.
Ο Δρ Βον Κούπερ, μικροβιολόγος από το Πανεπιστήμιο του Πίτσμπουργκ και συν-συγγραφέας της εργασίας, λέει: «Αυτή η μορφή ζωής δεν υπήρξε ποτέ ούτε εξελίχθηκε, κατά συνέπεια, όλες οι βιολογικές αλληλεπιδράσεις θα ήταν διαφορετικές ή πιθανότατα δεν θα λειτουργούσαν.
«Δεν θέλουμε να περιορίσουμε αυτή την υπόσχεση για συνθετική βιολογία, αλλά η κατασκευή ενός βακτηρίου καθρέφτη δεν αξίζει τον κίνδυνο».
Τι είναι τα «βακτήρια-καθρέφτες»
Ακριβώς όπως το αριστερό μας χέρι είναι μια κατοπτρική εικόνα του δεξιού χεριού μας, πολλά βιολογικά μόρια έχουν επίσης ένα αριστερό και δεξιόστροφο μόριο καθρέφτη.
Ο συγγραφέας καθηγητής Γκρέγκορι Γουίντερ, βραβευμένος με Νόμπελ βιολόγος από το Πανεπιστήμιο του Κέιμπριτζ, είπε: «Ο κίνδυνος της ζωής καθρέφτη, ιδιαίτερα των βακτηρίων καθρέφτη, είναι ότι οι ζωντανοί οργανισμοί δεν θα αναγνωρίσουν τους αντίστοιχους καθρέφτες τους ως “ξένουςκαι δεν έχουν τις φυσικές άμυνες για να προστατευθούν από τις επιθέσεις τους».
«Για παράδειγμα, οι άνθρωποι θα πάλευαν να δημιουργήσουν αντισώματα ενάντια στα βακτήρια του καθρέφτη και δεν θα μπορούσαν να ελέγξουν μια μόλυνση. Παρόμοια επιχειρήματα ισχύουν για όλους τους άλλους ζωντανούς οργανισμούς, συμπεριλαμβανομένων των φυτών που υφίστανται επίθεση από βακτήρια καθρέφτη».
Ακόμα κι αν οι άνθρωποι βρουν έναν τρόπο να αμυνθούν από αυτή τη νέα απειλή, τα βακτήρια καθρέφτη θα μπορούσαν να αποσταθεροποιήσουν μεγάλα τμήματα του οικοσυστήματος του κόσμου.
Ο συγγραφέας Dr Nicholas Talbot, ειδικός σε φυτικές ασθένειες και εκτελεστικός διευθυντής του εργαστηρίου Sainsbury είπε: «Φαίνεται πολύ πιθανό ότι ένα βακτήριο καθρέφτη θα μπορούσε να μολύνει ορισμένα φυτά. Εάν οι μεγάλες καλλιέργειες τροφίμων ήταν ευάλωτες, ο αντίκτυπος θα ήταν καταστροφικός – μαζί με τις άλλες επιπτώσεις».
Τα καλά νέα είναι ότι η τεχνολογία για τη δημιουργία ζωής – καθρέφτη είναι ακόμα μακριά.